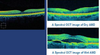

Elderly Eye Disease Flashcards
1
Q
Cataract
A
- Opacification of the lens of the eye
- Common - prevalence of 100% in >80 years
- Causes:
- Senile (70% of >70 years)
- Secondary to ocular disease (i.e. uveitism angle closure glaucoma, myopia, trauma)
- Secondary to systemic disease or treatment (i.e. DM, myotonic dystrophy, steroids, chloropromazinre, amiodarone, radiation)
- Indications for surgery:
- Symptomatic (comorbidity is not a contraindication)
- Reduction in visual function (not Snellen VA)
- Distance (faces, driving, TV)
- Near (reading, music, sewing, iPhone)
- Driving, work, occupational
- Optical (anisometropia, diplopia)
- Glare and dazzle
- Medical (screening DM, phacomorphic, ecyopia)
- Low vision (restoration of navigation)
- Surgical highlights:
- Day case - local anaesthetic, follow-up by opticians
- Complications of surgery
- Immediate:
- Choroidal haemorrhage
- Dropped nucleus
- Vitreous loss/capsular non-integrity
- Corneal burns
- Corneal epithelial defect
- Early (<24 hours):
- Raised IOP
- Corneal oedema
- Flat AC
- Haemorrhage
- Wound
- Iris prolapse
- Incomplete vitrectomy
- Uveitis
- Raised IOP
- Intermediate: (2-7 days)
- Endophthalmitis
- Corneal oedema
- Lens matter residuum
- SIDS
- Sutures
- Late (>2 weeks)
- Posterior capsular opacification
- Cystoid macular oedema
- Capsular phimosis
- Refractive
- IOL ectropia
- Retinal detachment
- Glaucoma
- Propioniform capsulitis
- Uveitis
- Immediate:
2
Q
Glaucoma
A
- Acute
- Angle closure (ACAG)
- Rubeotic
- Rare
- Chronic
- Open angle (POAG/COAG/NTG)
- 1:40 over 60 years
3
Q
Acute Angle Closure Glaucoma
A
- Iris bulges forward and seals off the trabecular meshwork from the anterior chamber preventing aqueous humour from draining.
- Risk factors include:
- Increasing age
- Female gender
- FHx
- Chinese and east asian ethnic origin
- Shallow anterior chamber
- Certain medications (adrenergic medications - noradrenalin, anticholinergic medications - oxybutuynin and solifenacin, TCAs - amitriptyline)
- Presentation:
- Acutely painful eye
- Blurred vision
- Coloured haloes
- Frontal headache
- Nausea and vomiting
- Acute angle closure crisis
- Reduced vision
- Hazy cornea
- Pupil fixed
- Pupil mid-dilated/oval
- Shallow anterior chamber +/- systemically unwell +/- nausea
- Red flags
- Elderly
- Long sighted (hypermetropic)
- Cataract
- +/- recent iotrogenic dilation
- Vomit bowl and drip/laparotomy/autumn
- Management
- Refer to ophthalmology
- Break attack - topical and systemic ocular antihypertensives (diamox/mannitol +/- miotics (i.e. pilocarpine) +/- topical steroids)
- Definitive treatment - YAG laser PI or argon laser iridoplasty, lens extraction

4
Q
Aqueous Dynamics
A

5
Q
Primary Open Angle Glaucoma
A
- Gradual increase in resistance through the trabecular meshwork making it difficult for aqueous humour to flow through and exit the eye. This causes pressure to build within the eye causing glaucoma.
- Optic neuropathy with characteristic visual field loss
- Primary controllable risk factor is intraocular pressure over sustained period
- Other risk factors include:
- Age
- Family history
- Black ethnic origin
- Nearsightedness (myopia)
- Occular history
- Presentation:
- Affects peripheral vision
- Gradual loss until patients experience tunnel vision
- Can also have pain, headaches, blurred vision and haloes around lights
- Measuring intraocular pressure:
- Non-contact tonometry - puff of air at cornea, measures response, less accurate
- Goldman applanation tonometry - gold standard, device attached to slit lamp applies pressure to cornea to measure
- Diagnosis:
- Goldmann applanation tonometry
- Fundoscopy for optic disc cupping
- Visual field assessment for peripheral vision loss
- Management:
- 1st - Prostaglangin analogue eye drops - increase uveoscleral outflow
- BBs - reduce production of aqueous humour (i.e. timolol)
- Carbonic anhydrase inhibitors - reduce production of aqueous humour (i.e. dorzolamide)
- Laser trabeculoplasty (SLT, ALT) - enlarges holes in trabecular meshwork to increase outflow
- Trabeculectomy enhanced MMC/5-FU
- Tubes, shunts and microstents

6
Q
Macular degeneration
A
- Pathophysiology:
- Macular made of 4 lauyers - choroid is bottom layer that contains vessels providing blood supply, Bruch’s membrane is the layer above, then the retinal pigment epithelium and finally the photoreceptors.
- In AMD drusen (deposits of proteins and lipids) appear between the RPE and Bruch’s - smaller than 63 micrometers are normal but larger and greater numbers can be a sign of AMD.
- Other features include atrophy of the RPE and degeneration of the photoreceptors.
- In wet AMD there are new vessels growing from the choroid layer which can leak and cause oedema.
- Dry more common (90% of cases) - wet carries worse prognosis
- Risk factors include:
- Age
- Smoking
- White or chinese ethnic origin
- FHx
- CV disease
- Presentation:
- Distortion and blind spots/dark areas
- Loss of central visual field
- Reduced visual acuity
- Crooked or wavy appearance to straight lines
- Wet presents more acutely
- Examination:
- Reduced acuity
- Scotoma (central patch of vision loss)
- Amsler frid test (assess distortion of straight lines)
- Fundoscopy (drusen)
- Slit-lamp biomicroscopic fundus examination
- OCT
- Fluorescein angiography
- Management:
- Dry - avoid smoking, control BP, vitamin supplementation
- Wet - intravitreal lucentis (anti-VEGF)
7
Q
Retinal artery occlusion
A
- Central retinal artery occlusion
- Emboli from carotid or heart (endocarditis, AF), thrombus, GCA
- Sudden painless (GCA included) fulminant unilateral loss of vision and RAPD, pale retina with cherry red fulvia
- Refer to ophthalmology (exclude GCA, reduced IOP?>, medical workup - carotids)
- Branch retinal artery occlusion
- Part of retina ischaemic - search for emboli
- Management:
- Ocular massage
- Removing fluid from the anterior chamber to reduce intraocular pressure
- Inhaling carbogen to dilate the artery
- Sublingual isosorbide dinitrate to dilate the artery

8
Q
Retinal venous occlusion
A
- Central retinal vein occluison
- CVS disease, elderly
- Sudden painless (GCA excluded) fulminant unilateral loss of vision and RAPD
- Refer ophthalmology (BP, DM, viscosity, smoking, age, IOP)
- Branch retinal artery occlusion
- Part of retina ischaemic
- Fundoscopy:
- Flame and blot haemorrhages
- Optic disc oedema
- Macula oedema
- Complications of RVO
- Systemic - CVS disease
- Ocular - neovascularisation secondary to ischaemia (laser photocoagulation to treat) and macular oedema (anti-VEGF to treat)
9
Q
Ischaemic optic neuropathies
A
- Smiliar pathology to RVO due ischaemic of optic nerve leading to loss of function - but choroidal circulation
- Arteritic - think GCA
- Jaw claudication, polymyalgia
- CRP, ESR, platelets, Hb, temporal artery biopsy
- High dose steroids - early move to biologics
- Non-arteritic - ischaemia due to inadequate perfusion
- Low BP - overmedicated antihypertensives
- Anaemia
- Hypovolaemia
10
Q
Dry eyes
A
- Mechanisms
- Hyperosmolality (causes inflammation)
- Tear instability (overt, subtle, occular protection index, TGBUT/blink interval)
- Management
- Level 1
- Education and environmental/dietary modifications (Ω3 fish/flax oil)
- Preserved artificial tear substitutes, gels, ointments
- Remove offending systemic medicaitons
- Eyelid therapy/lid hygiene
- Level 2a
- Non-preserved artificial tear substitutes
- Anti-inflammatory agents
- Topical/systemic omega-3 fatty acids
- Tetracyclines (for meibomianitis, rosacea), azithromycin oral and topical
- Level 2b
- Topical corticosteroids
- Topical ciclosporin A
- Punctal plugs (after control of inflammation)
- Secretagogues
- Moisture chamber spectacles
- Level 3
- Autologous serum, umbilical cord serum, contact lenses, permanent punctal occlusion
- Level 4
- Systemic anti-inflammatories
- Surgery
- Lid surgery
- Tarsorrhaphy
- Mucous membrane grafting
- Salivary gland duct transposition
- Amniotic membrane transplantation
- Level 1

11
Q
Blepharitis
A
- Inflammatory lid condition
- Dermodex, staphlococcus epidermidis
- Symptoms:
- Lid reddening
- Lid thickening
- Crusts
- Collarettes
- Stye
- Concretions
- Madarosis
- Poliosis
- Metaplastic lashes
- Frothy tears
- Notches
- TFBU
- Keratitis - marginal
- Sterile infiltrates
- Corneal vascularisations
- Angular chelitis
- Rosacea facies
- Management:
- Lid hygiene
- Wipes
- Tear substitutes
- Non-allergic make-up
- Preservative free drops
- Recognise acne rosacea
- In acute phase add topical steroids and antibiotics (azithromycin, tetracycline)
12
Q
Posterior vitreous detachment
A
- Vitrenous body is gel inside the eye
- Made up of collagen and water
- Detachment is where it comes away from the retina
- Presentation:
- Painless
- Spots of vision loss
- Floaters
- Flasking lights
- No treatment necessary - symptoms resolve as brain adjusts
- Must exclude risk of retinal tear or detachment


